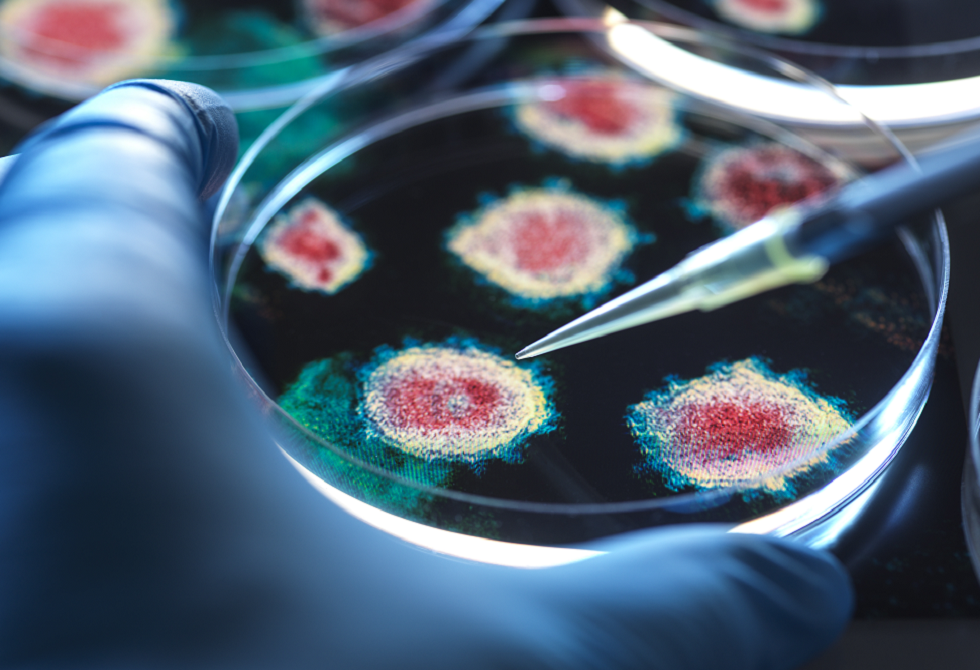

- برلمانا المغرب وفرنسا: السيادة المغربية على الأقاليم الجنوبية أساس الشراكة الاستثنائية
- الحكومة السورية تعلن اتفاقا شاملا لوقف النار ودمج قسد في الجيش
- فضايح صفقات "كوب 22".. محكمة مراكش ضربات البرلماني بنسليمان والعمدة السابق بلقايد بعامين ديال الحبس النافذ لكل واحد فيهم مع أداء 4 مليون ديال الدرهم لفائدة الدولة .
- انتخاب عمر هلال لرئاسة لجنة بناء السلام بالأمم المتحدة
- بهاد الفيضانات خاص حلول لنقل المياه وتصريفها.. نسبة ملء السدود غادا لكثر من 60 فالمية: هاد الصباح سجلت 57,46 فالمائة .
- المغرب يدعو الاتحاد الأوروبي للانتقال من شراكة “الجار” إلى “الحليف”
- برون بيفي: العلاقات المغربية الفرنسية تدخل “عصرا ذهبيا”.. ومستقبلنا مشترك في مواجهة التحديات
- مياه اللوكوس تواصل محاصرة القصر الكبير.. خيام الجيش واجتماع حكومي لإنقاذ المدينة (فيديوهات)
- "اتفاق شامل" بين دمشق و"قسد" في الحسكة.. وهذه أهم بنوده
- "تُذكرني بمشهد حرب العراق".. البرادعي يُعلق على تهديدات ترامب لإيران
- على الخريطة.. مدى أسلحة إيران والدول القابعة بمرماها بالكيلومتر
- الصفقة تمت.. موهبة مصر إلى برشلونة وهذه شروط الانتقال
- طقس اليوم.. زخات مطرية ورياح قوية في عدة مناطق
- فالمغرب.. مع الأسف: إنجازات كبار ونقاشات صغار. ميناء الناظور ودعم اوربي للحكم الذاتي خدمة كبيرة ب"الدق والسكات" .
- الجيش الإسرائيلي يعلن تصفية 3 مسلحين بغارة على نفق شرق رفح
- تحليل: تحالف باكستان مع السعودية وتركيا فرصة محفوفة بالمخاطر
- جنازة "دامية" في السودان.. غارة تقتل 15 معزيا داخل المقابر
- أردوغان يهاتف بزشكيان بشأن أزمة إيران وأميركا
إسرائيل تعلن قتل "ثلاثة مسلحين" قرب رفح في قطاع غزة
أعلن الجيش الإسرائيلي، صباح الجمعة، أنه شن ضربات خلال الليل على "ثمانية مسلحين" وقتل ثلاثة منهم في منطقة رفح بجنوب قطاع غزة، وذلك في ظل وقف إطلاق النار في القطاع.
ووقع الحادث في محيط معبر رفح الحدودي مع مصر الذي يعد نقطة دخول حيوية للمساعدات الإنسانية، والذي يترقب سكان القطاع المنهكون إعادة فتحه.
وأفاد الجيش، في بيان، بأن الجنود رصدوا قبيل الفجر "ثمانية مسلحين" خرجوا من "بنية تحتية تحت الأرض" في شرق رفح و"قام سلاح الجو الإسرائيلي بضرب ثلاثة منهم وتصفيتهم".
وأضاف البيان أن ضربات أخرى نفّذت في اتجاه المناطق التي حاول العناصر المتبقون الفرار إليها، وأن الجنود "يواصلون عمليات التفتيش في المنطقة لرصد وتصفية جميع المسلحين".
وأكد الجيش أن "القوات تبقى منتشرة طبقا لاتفاق وقف إطلاق النار وستواصل العمل على إزالة أي تهديد آني"، بدون كشف أي معلومات حول نوع الأسلحة التي كان عناصر المجموعة يحملونها.
وتنصّ خطة وقف إطلاق النار في غزة، التي تم التوصل إليها بضغط من الولايات المتحدة ودخلت حيّز التنفيذ في 10 أكتوبر، على إعادة جميع الرهائن المحتجزين في القطاع في مرحلتها الأولى.
وتنص المرحلة الثانية من الخطة على نزع سلاح حركة حماس، والانسحاب التدريجي للجيش الإسرائيلي الذي لا يزال يسيطر على نحو نصف قطاع غزة، ونشر قوة دولية.
 المصدر:
سكاي نيوز
المصدر:
سكاي نيوز